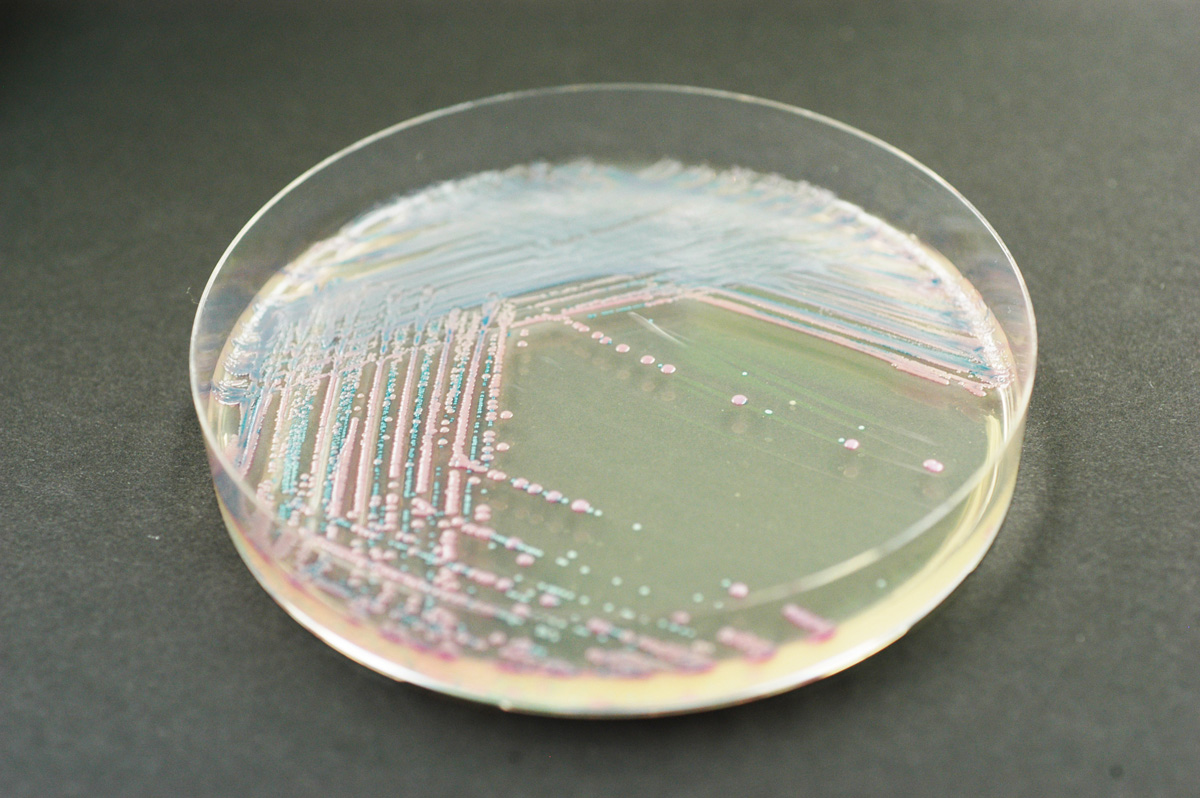
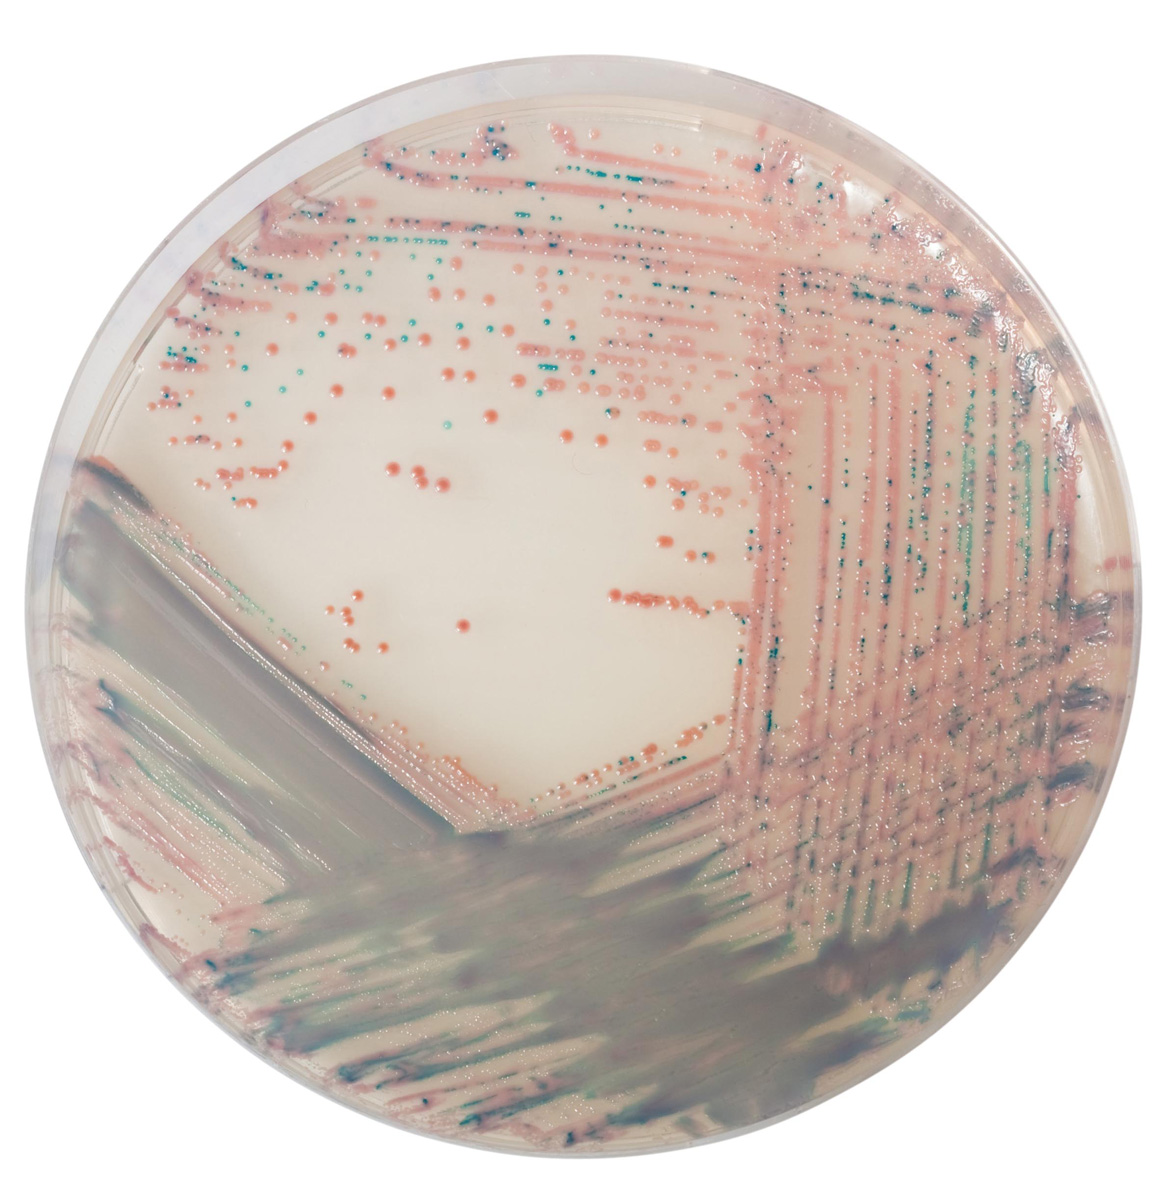

À propos du produit
Milieu chromogène pour l'isolement de Staphylococcus aureus.
Produits
Milieux et suppléments
Géloses Chromogènes CHROMagar
CHROMAGAR STAPHYLOCOCCUS AUREUS
CHROMAGAR STAPHYLOCOCCUS AUREUS

Milieu chromogène pour l'isolement de Staphylococcus aureus.